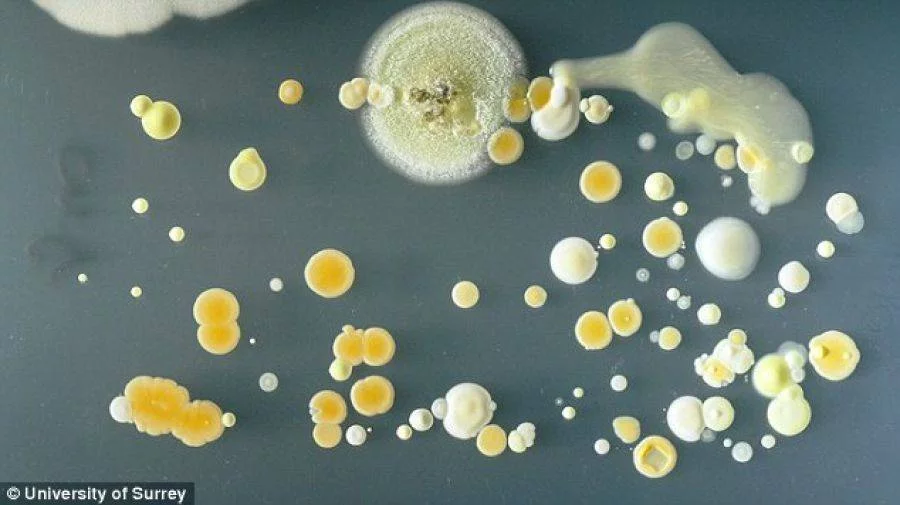

Колкото повече ползвате смартфона си, толкова по-голям е шанса той да е пълен с бактерии. Снимките, които публикуваме, показват ясно това. В повечето случаи, тези бактерии за безобидни и се лепят по екрана, ако го ползвате с мръсни ръце.

Понякога обаче на телефоните се откриват микроорганизми, които могат да доведат до инфекции, хранително отравяне, кожни обриви и дори отравяне на кръвта. Това показва изследване на бактериолози от университета в Съри, които решили да проверят нивото на мръсотия върху телефоните ни. Те поставили собствените си телефони в среда, която спомага развитието на микроорганизмите и били шокирани от резултата.
В няколко случая била открита болестотворната бактерия Стафилококус ауреус. Смята се, че 20 % от хората са нейни носители, като най-често тя се развива в носовите канали. Много хора са само носители на бактерията, без да се разболяват.
Когато обаче се наруши целостта на кожата, може да предизвика рани и инфекции. А стафилококовите бактерии могат лесно да се разпространят чрез различни повърхности от човек на човек.
Друга наблюдавана бактерия върху смартфоните е Бацилус микоидес, която най-често се среща в почвата. Тя спомага за развитието на други опасни бактерии и гъбички.
Ръководителят на изследването, д-р Саймън Парк коментира, че смартфоните очевидно не съхраняват само номерата на нашите познати, снимки и видео, а и цялата ни история на физическия ни допир с други хора и околната среда.

Най-шокиращото заключение е обаче, че обикновения мобилен апарат носи 18 пъти повече потенциално опасни микроби, отколкото бутона за пускане на водата в мъжка тоалетна. И това е доказано от последни научни тестове. По-лошото е, че поне една четвърт от апаратите са толкова мръсни, че съдържат над 10 пъти повече бактерии от приемливото ниво. Единият от изследваните апарати пък толкова изцапан, че без проблем можел да причини стомашно разстройство на притежателя си. В крайна сметка от „представителната извадка“ от 30 телефона, британските учени стигат до извода, че от 63 млн. използвани телефона във Великобритания, 14,7 млн. са потенциална опасност за здравето.